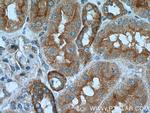
Caspase 2/p18 Antibody in Immunohistochemistry (Paraffin) (IHC (P))

Search
Proteintech
Caspase 2/p18 Polyclonal Antibody
{{$productOrderCtrl.translations['antibody.pdp.commerceCard.promotion.promotions']}}
{{$productOrderCtrl.translations['antibody.pdp.commerceCard.promotion.viewpromo']}}
{{$productOrderCtrl.translations['antibody.pdp.commerceCard.promotion.promocode']}}: {{promo.promoCode}} {{promo.promoTitle}} {{promo.promoDescription}}. {{$productOrderCtrl.translations['antibody.pdp.commerceCard.promotion.learnmore']}}
产品信息
10436-1-AP
种属反应
宿主/亚型
分类
类型
抗原
偶联物
形式
浓度
规格
纯化类型
保存液
内含物
保存条件
运输条件
产品详细信息
Immunogen sequence: MAADRGRRI LGVCGMHPHH QETLKKNRVV LAKQLLLSEL LEHLLEKDII TLEMRELIQA KVGSFSQNVE LLNLLPKRGP QAFDAFCEAL RETKQGHLED MLLTTLSGLQ HVLPPLSCDY DLSLPFPVCE SCPLYKKLRL STDTVEHSLD NKDGPLCLQV KPCTPEFYQT HFQLAYRLQS RPRGLALVLS NVHFTGEKEL E (18-217 aa encoded by BC002427)
靶标信息
This gene encodes a protein which is a member of the cysteine-aspartic acid protease (caspase) family. Sequential activation of caspases plays a central role in the execution-phase of cell apoptosis. Caspases exist as inactive proenzymes which undergo proteolytic processing at conserved aspartic residues to produce two subunits, large and small, that dimerize to form the active enzyme. The proteolytic cleavage of this protein is induced by a variety of apoptotic stimuli. Alternative splicing of this gene results in multiple transcript variants that encode different isoforms.
仅用于科研。不用于诊断过程。未经明确授权不得转售。
生物信息学
蛋白别名: CASP-2; CASP2; caspase 2 apoptosis-related cysteine peptidase; Caspase-2; ICH-1 protease; NEDD-2; Neural precursor cell expressed developmentally down-regulated protein 2; Protease ICH-1; protein phosphatase 1, regulatory subunit 57; unnamed protein product
基因别名: CASP-2; CASP2; ICH-1; ICH1; MRT80; NEDD-2; NEDD2; PPP1R57
UniProt ID: (Human) P42575, (Mouse) P29594, (Rat) P55215
Entrez Gene ID: (Human) 835, (Mouse) 12366, (Rat) 64314